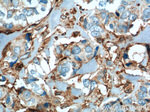
SFXN3 Antibody in Immunohistochemistry (Paraffin) (IHC (P))

Search
Proteintech
SFXN3 Polyclonal Antibody
{{$productOrderCtrl.translations['antibody.pdp.commerceCard.promotion.promotions']}}
{{$productOrderCtrl.translations['antibody.pdp.commerceCard.promotion.viewpromo']}}
{{$productOrderCtrl.translations['antibody.pdp.commerceCard.promotion.promocode']}}: {{promo.promoCode}} {{promo.promoTitle}} {{promo.promoDescription}}. {{$productOrderCtrl.translations['antibody.pdp.commerceCard.promotion.learnmore']}}
产品信息
15156-1-AP
种属反应
宿主/亚型
分类
类型
抗原
偶联物
形式
浓度
规格
纯化类型
保存液
内含物
保存条件
运输条件
产品详细信息
Immunogen sequence: MESKMGELP LDINIQEPRW DQSTFLGRAR HFFTVTDPRN LLLSGAQLEA SRNIVQNYRA GVVTPGITED QLWRAKYVYD SAFHPDTGEK VVLIGRMSAQ VPMNMTITGC MLTFYRKTPT VVFWQWVNQS FNAIVNYSNR SGDTP (1-144 aa encoded by BC000124)
靶标信息
Mitochondrial serine transporter that mediates transport of serine into mitochondria, an important step of the one-carbon metabolism pathway (PubMed:30442778). Mitochondrial serine is converted to glycine and formate, which then exits to the cytosol where it is used to generate the charged folates that serve as one-carbon donors. Also catalyzes an electroneutral exchange of tricarboxylate, dicarboxylate, or phosphoenolpyruvate across the mitochondrial inner membrane.
仅用于科研。不用于诊断过程。未经明确授权不得转售。
生物信息学
蛋白别名: Sideroflexin-3; tricarboxylate carrier; tricarboxylate carrier-like protein; unnamed protein product
基因别名: BA108L7.2; SFX3; SFXN3; SLC56A3; TCC
UniProt ID: (Human) Q9BWM7, (Rat) Q9JHY2, (Mouse) Q91V61
Entrez Gene ID: (Human) 81855, (Rat) 65042, (Mouse) 94280